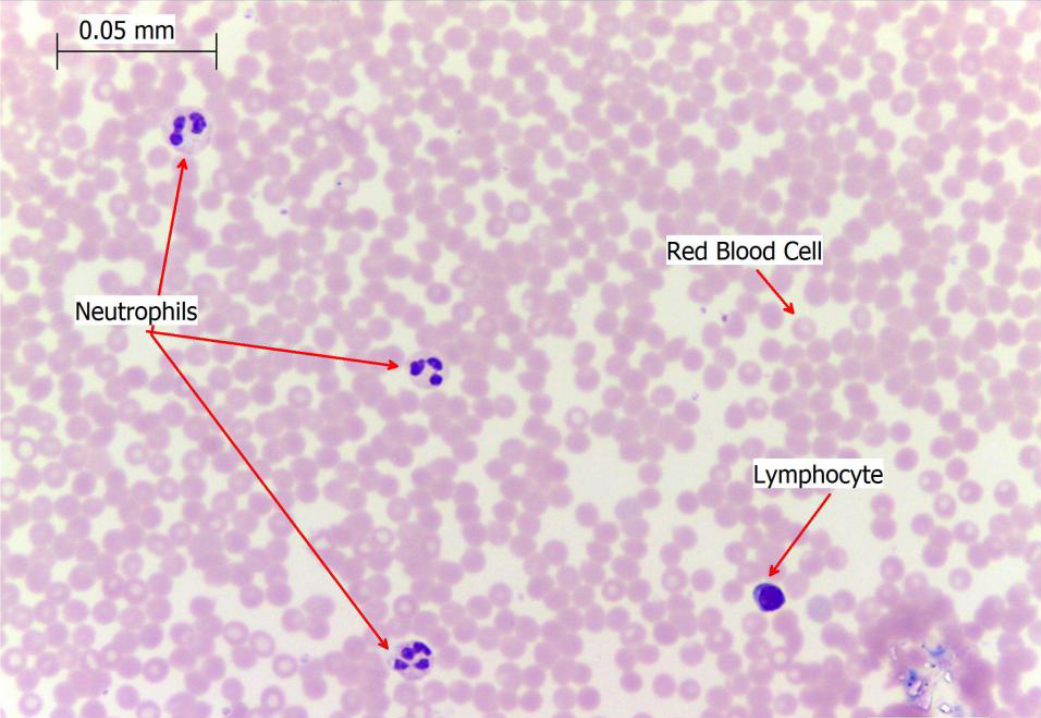
term image
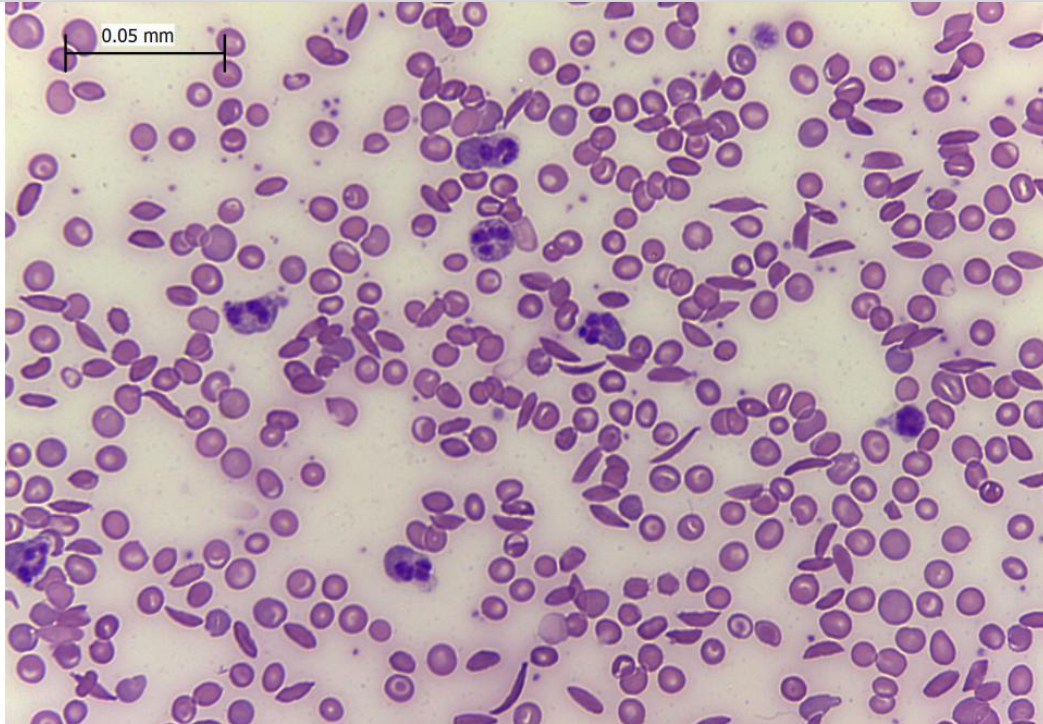
term image

Micrograph slides and diagrams (ECG and Resp)
1/45
There's no tags or description
Looks like no tags are added yet.
Name | Mastery | Learn | Test | Matching | Spaced | Call with Kai |
|---|
No analytics yet
Send a link to your students to track their progress
46 Terms

Simple Squamous epithelium

Columnar epithelium

ciliated columnar epithelium

human skin epidermis

stratified squamous epithelium

simple cuboidal epithelium

human skin subcutaneous layer

adipose

human skin dermis

elastic cartilage

bone
blood
sickle cell anemia

skeletal muscle

smooth muscle

cardiac muscle

motor neurons

human artery and vein

human artery and vein

mammal liver

liver portal

fundic stomach

mammal kidney

kidney cortex

kidney medulla

mammal graafian folicle

graafian follicle

mammal epididymis

mammal epididymis

onion root tip

onion root tip

ranunculus root

ranunculus root vascular tissue

branch root

lenticel

MONOCOT stem (scattered bundles)

zea stem vascular bundle (MONOCOT)

DICOT stem ring of vascular bundles

helianthus stem (DICOT)

helianthus stem vascular bundle (DICOT)

coleus stem tip

syring (lilac) leaf







